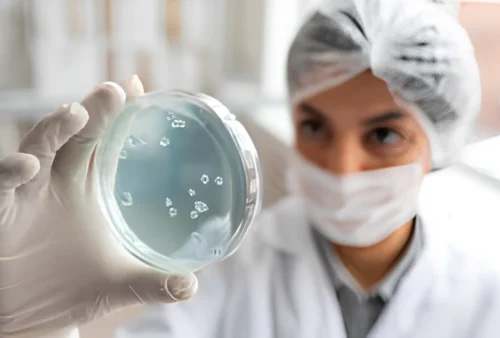
cytopathology (1)

Cytopathology
We do both aspiration cytology & exfoliative cytology. Aspiration cytology is done by performing FNAC’s & guided FNAC’s of lymph nodes, thyroid gland & other swellings. Exfoliative cytology includes pap smears (gynaecological) & body fluid cytology (cerebrospinal fluid, bronchoalveolar lavage, pleural fluid, ascitic fluid & urine).
